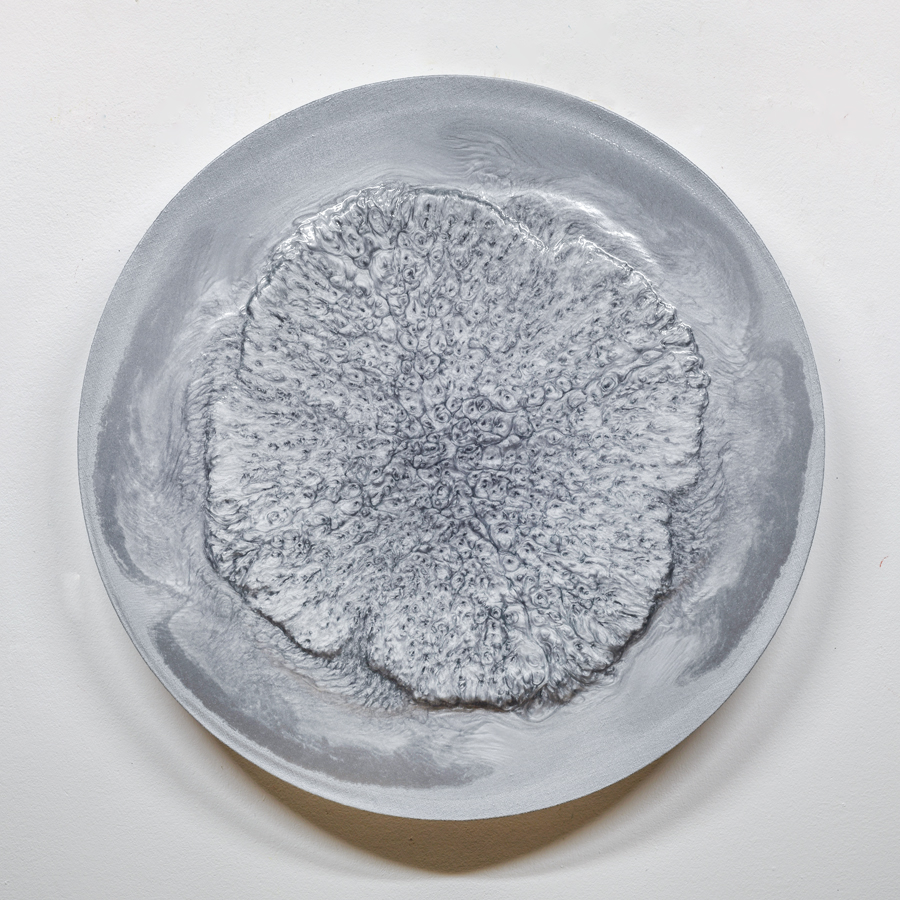

MILAN HOUSER
Milan Houser est né en 1971 en République tchèque. Son talent s’est vu récompensé par des prix honorifiques, dont celui de la très prestigieuse Fondation Stipendium Pollock – Krasner en 2005. Ses œuvres font partie de la collection permanente de la Galerie Nationale de Prague et de nombreuses collections internationales privées notamment en République tchèque, France, Italie, Allemagne, ainsi qu’aux Etats-Unis. À travers les couleurs et son espace, son aire d’étendue, il ouvre un autre espace de couleur qui permet de percevoir le mouvement.
Les intensités de lumière, leur proximité avec certaines ombres qui nous offrent l’expérience d’une agitation abstraite. Milan Houser ne “peint” pas au sens propre du terme, mais “coule” sa peinture en volume sur la toile posée à l’horizontal, divisant le tableau en sections bien définies. Les zones ainsi créées – que l’Artiste dénomme “chambres”- ne présentent pas de limites distinctes puisque la peinture se répartie de façon aléatoire. Une nouvelle œuvre prend vie, née de matières et de formes inattendues. L’espace se comble alors sans répit, créant un effet à la fois glacé, élastique et homogène. Le public est depuis conquis par ces tableaux, aux couleurs flirtant entre éclat et subtilité. Retrouvez ses dernières séries dans les galeries Marciano Contemporary.
Untilted – MH5003
Vernis et pigments sur toile
50 cm ∅
Unique
Untilted – MH5004
Vernis et pigments sur toile
50cm ∅
Unique
Untilted – MH10014
Vernis et pigments sur toile
100 cm ∅
Unique
Untilted – MH10015
Vernis et pigments sur toile
100 cm ∅
Unique
Untilted – MH 94
Vernis et pigments sur toiles
125 cm ∅
Unique
Untilted – MH5005
Vernis et pigments sur toile
50 cm ∅
Unique
Untilted – MH10020
Vernis et pigments sur toile
100 cm ∅
Unique
Untilted – MH9012
Vernis et pigments sur toile
90 cm ∅
Unique
Untilted – MH15024
Vernis et pigments sur toile
120 cm ∅
Unique
Untilted – MH8010
Vernis et pigments sur toile
80 cm ∅
Unique
Untilted – MH5006
Vernis et pigments sur toile
50 m ∅
Unique
Untilted – MH5008
Vernis et pigments sur toile
50cm ∅
Unique
Untilted – MH10017
Vernis et pigments sur toile
100 cm ∅
Unique
Untilted – MH12522
Vernis et pigments sur toile
125 cm ∅
Unique
Untilted – MH708
Vernis et pigments sur toile
90 x 120 cm | 35 x 47 in
Unique